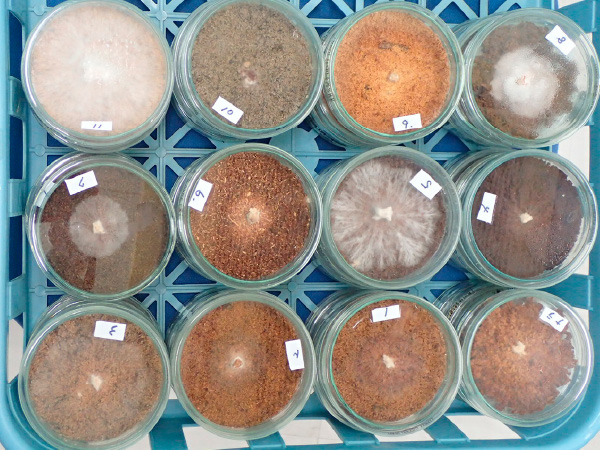

今後の研究開発
今後の研究開発の方向性

企業は、その時々の社内事情や社会情勢などに対して、柔軟に対応する必要があります。世界的な不況などで危機的な経済状況の中、「きのこ種菌業」は業界としての在り方や存続自体が問われようとしています。弊社は、世界初のしいたけ菌床栽培用品種「北研600号」の開発から始まった「しいたけ菌床栽培技術の開発と普及」を大ヒットにつなげて事業拡大を図ってきましたが、100年企業を目指す中で今後どのように事業を発展させていくのか、方向性が問われる非常に難しい局面にあります。
このような状況の中、食用菌類研究所が行なうべき研究開発の方向性は、「現在」、「拡大」、「未来」の三つの視点からの、事業拡大の礎となる基盤整備であると考えています。
「現在」の視点では、これまで進めてきた事業継続のための下支えを確実に行なうことです。しいたけ菌床栽培システムは成熟していくつかの方法に分化しており、目的に応じた品種開発はもとより、安定した品質と性能を発揮できる種菌提供などが求められます。
「拡大」の視点では、現在保有している弊社の強みを活かした事業展開です。例えば、しいたけ以外の新規のきのこや、一般に栽培されている食用きのこについて、これまでとは違った切り口から開発を行なうことで新たな需要を作り出します。さらに、それらを起点とした食用きのこの流通販売や六次化などへの展開が考えられます。弊社では、(公財)岩手生物工学研究センターとの共同研究によって、すでに「日持ち」に関わる遺伝子を特定し、そのマーカー化にも成功しています。また、近年、クローズアップされている機能性についても、いくつか有望な性質を特定できています。これらの資源を活かして食用きのこが持っている食品としての有用性を積極的にアピールしていきたいと考えています。
「未来」の視点では、国内のみならず海外を見据えたすべてのきのこ消費者への展開です。そのためには、さまざまな多様性に対応できる品種開発や技術開発が必要になります。
以上のように、これまで進めてきた方向に沿った改善や改良を行なうだけでなく、新たな事業開発に向けた枠組を創造することが、重要な使命であると考えています。

しいたけ育種と品種登録
- 省エネ対応(例:高温菌、低温菌)
- 省力対応(例:管理容易)
- 新基材適合(例:針葉樹、培地再利用)
- 新技術導入(例:DNAマーカー利用)

様々なきのこ種の育種
- えのきたけ
- まいたけ
- あらげきくらげ
- やまぶしたけ
- ぶなしめじ
- はなびらたけ
- たもぎたけ

栽培技術の開発と特許取得
- 品種に合う有利な栽培法
- 収量性や品質向上に資する栽培法
- 省力、省エネ的な栽培法
- 次世代の栽培技法

菌株管理、および技術開発
- 売品種菌株の保存管理
- 多様な遺伝資源の保存管理
- 菌株の活力維持や回復技法の開発
- 長期(数十年)保管技法の開発

栽培資機材の開発と商標登録
- 害虫防除に資する資機材の開発
- 品種に合う栽培袋等の開発
- 栄養体の開発(有機JAS対応など)
- 未利用樹種や栄養体原料の探索

きのこパワーの新分野活用
- バイオ燃料製造への利用検討
- 菌糸体の有効利用
- 環境浄化への利用
- 健康機能性成分の活用
